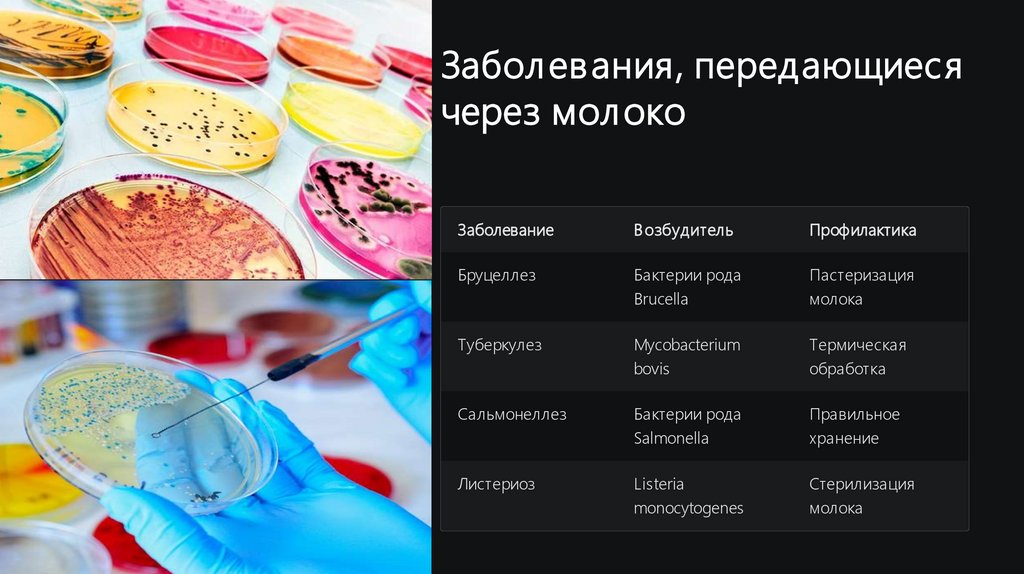

Similar presentations:
Когда молоко может быть опасно для здоровья?
1.
Когда молоко может бытьопасно для здоровья?
Молоко является одним из основных продуктов питания для
многих людей. Однако при определенных условиях оно может
представлять опасность для здоровья.
Наш проект исследует риски, связанные с употреблением
молока, и предлагает рекомендации по его безопасному
использованию.
2.
Цель и задачи проектаЦел ь иссл едования
Изучение характеристик и свойств молока, влияющих на
здоровье человека.
История и разнообразие
Исследование происхождения и видов молока.
Потенциал ь ны й вред
Анализ рисков употребления молока.
Пол езны е свойства
Выявление условий безопасного употребления молока.
3.
Сколько же лет молоку?1
8000 лет до н.э.
Первые свидетельства употребления молока. Одомашнивание
коров и коз.
2
3000 лет до н.э.
Появление первых технологий обработки молока в древних
цивилизациях.
3
19 век
Луи Пастер разрабатывает процесс пастеризации.
4
Современность
Промышленное производство и разнообразие молочных продуктов.
4.
Виды молокаКоровь е мол око
Козь е мол око
Овечь е мол око
Кобы л ь е молоко
Самый
Легче усваивается.
Высокая жирность.
Низкое содержание жира.
распространенный вид.
Содержит меньше
Используется для
Богато витамином С.
Богато кальцием и
аллергенов.
производства сыров.
витаминами группы В.
5.
Типы молока по сы рь юЦел ь ное мол око
Натуральный продукт без изменения состава.
Нормализованное мол око
Откорректированное содержание жира.
Восстановл енное мол око
Производится из сухого молока и воды.
Тип молока напрямую влияет на его питательные свойства и возможные риски для здоровья.
6.
Виды молока потермообработке
Парное молоко
Свежее, необработанное. Может содержать патогенные
микроорганизмы.
Пастеризованное молоко
Нагрев до 65-95°C. Уничтожает большинство бактерий.
Кипячёное и топлёное молоко
Длительный нагрев. Разрушает часть полезных веществ.
Стерилизованное и ультрапастеризованное
Высокотемпературная обработка. Долгий срок хранения.
7.
Химический состав молокаБ ел ки
Вода
3-4%. Казеин и сывороточные белки.
85-88% состава. Основа молока.
1
2
Жиры
3
Минерал ы и витамины
Кальций, фосфор, витамины A, D,
группы B.
5
4
3-5%. Включают насыщенные и
ненасыщенные кислоты.
Лактоза
4-5%. Молочный сахар,
вызывающий непереносимость.
8.
Хранение молокаТемпературны й режим
Оптимальная
температура: +2...+6°C
Не допускать
замораживания
Избегать хранения при
комнатной температуре
Признаки порчи
Кислый запах
Изменение консистенции
Горький вкус
Сроки хранения
Парное молоко: до 2 часов
Пастеризованное: 3-7 дней
Ультрапастеризованное:
до 6 месяцев
9.
Вред молокаЛактозная непереносимость
Недостаток фермента лактазы вызывает расстройство
пищеварения.
Аллергические реакции
Белки молока могут вызывать аллергию у
чувствительных людей.
Гормональный дисбаланс
Современное промышленное молоко содержит гормоны.
Ожирение и диабет
Высококалорийные молочные продукты могут
способствовать метаболическим нарушениям.
10.
Забол евания, передающиесячерез молоко
Заболевание
В озбудитель
Профилактика
Бруцеллез
Бактерии рода
Brucella
Пастеризация
молока
Туберкулез
Mycobacterium
bovis
Термическая
обработка
Сальмонеллез
Бактерии рода
Salmonella
Правильное
хранение
Листериоз
Listeria
monocytogenes
Стерилизация
молока

cookery
cookery








